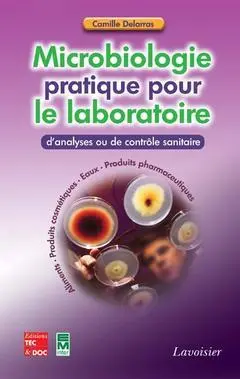
Microbiologie pratique pour le laboratoire d'analyses ou de contrôle sanitaire

Permet à tous ses détenteurs d'obtenir 5% de réduction sur tous les livres lors du retrait en magasin (réduction non cumulable avec les réductions de type étudiant).
Offre également un certain nombre d'avantages auprès de nos partenaires.
Avec les favoris, retrouvez dans un espace les sélections effectuées au fur et à mesure de vos navigations dans le site.
Constituez pour votre usage personnel vos listes de livres en prévisions d'achats futurs et votre sélection d'articles, dossiers, événements, vidéos ou podcasts préférés ou à découvrir plus tard...
Il suffit simplement de cliquer sur "Ajout Favori" sur chaque page qui vous intéresse pour les retrouver ensuite dans votre espace personnel.
Requiert un compte Mollat
Requiert un compte Mollat
- Auteur
- Delarras, Camille
Livres Camille Delarras
Editions médicales internationales
Editions médicales internationales
Lavoisier